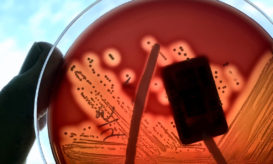
στρεπτόκοκκος

Διεισδυτικός στρεπτόκοκκος στα παιδιά: Λάθη στη διάγνωση και η «πίεση» στον γιατρό για αντιβίωση
Ψυχραιμία και όχι πανικό συνιστούν οι Παιδίατροι για τα αυξημένα περιστατικά διεισδυτικής στρεπτοκοκκικής νόσου που εντοπίζονται κατά τον...

Ψυχραιμία και όχι πανικό συνιστούν οι Παιδίατροι για τα αυξημένα περιστατικά διεισδυτικής στρεπτοκοκκικής νόσου που εντοπίζονται κατά τον...

Πρόκειται για μία σπάνια επιπλοκή σε άτομο που δεν φαίνεται να έχει κάποια υποκείμενα νοσήματα.

Έχουν τεθεί σε εφαρμογή όλα τα σχετικά πρωτόκολλα για τη διαχείριση του συμβάντος.

Η Ματίνα Παγώνη μίλησε για την έξαρση στα συμπτώματα του στρεπτόκοκκου και τους τρόπους αντιμετώπισής του.

Για μια ακόμη φορά το τελευταίο διάστημα, οι Φαρμακοποιοί βρίσκονται στο επίκεντρο διαμάχης. Αυτή τη φορά, με τους εργαστηριακούς...

Τα αίτια εντοπίζονται στις εξαγωγές, την έλλειψη πρώτης ύλης και τις τακτικές κάποιων φαρμακευτικών.

Ανησυχία και ερωτηματικά έχει προκαλέσει σε γονείς και επιστήμονες στην Ελλάδα, ο τελευταίος θάνατος παιδιού από διεισδυτική στρεπτοκοκκική νόσο...

Η ενημέρωση γύρω από τα κρούσματα στρεπτόκοκκου έχει λάβει μορφή χιονοστιβάδας αυτές τις μέρες.
Ο μικροοργανισμός διασπείρεται κυρίως μέσω σταγονιδίων κατά τον βήχα ή φτάρνισμα και με τη στενή επαφή.

Με τις τηλεοπτικές τους εμφανίσεις και σήμερα, γιατροί ενημερώνουν σωστά το κοινό και ηρεμούν την κατάσταση.

Από λοίμωξη του αναπνευστικού, η οποία προκλήθηκε από στρεπτόκοκκο της ομάδας Α έχασε τη ζωή του ο άτυχος 7χρονος...

Η πρόεδρος της ΕΙΝΑΠ μίλησε στην ΕΡΤ για τον στρεπτόκοκκο και εφίστησε την προσοχή των γονέων.

Το παιδί, σύμφωνα με πληροφορίες, είναι σε καλή κατάσταση με ήπια συμπτώματα και υπό αγωγή.

Πολλοί διαφορετικοί παράγοντες μπορούν να προκαλέσουν πονόλαιμο.

Χρειάζεται προσοχή καθώς μπορεί να εξελιχθεί σε σοβαρή κατάσταση υγείας.